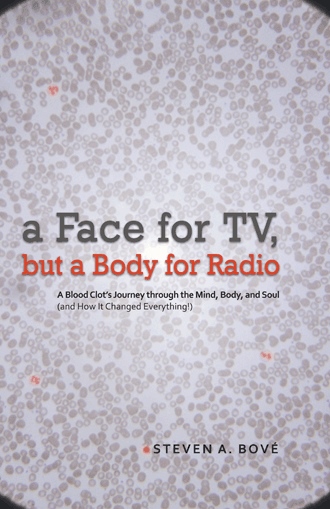

a Face for TV, but a Body for Radio
A Blood Clot’s Journey through the Mind, Body, and Soul (and How It Changed Everything!)
by
Book Details
About the Book
In 2004, Steven Bové almost lost his life. He had been married barely five months, and his baffling medical emergency made his new wife fear that she was about to become his widow. When excruciating pain, first felt during a workout, pushed him from doctor to doctor without answers, the newlyweds feared the worst. Soon he found himself in intensive care with his life hanging in the balance. The reason soon became apparent: blood clots were ravaging his body and shutting down his lungs. Even though complications nearly cost him his leg and his life, he battled onward.
Ten excruciating days later, Steven emerged from the hospital a changed man. His near-death experience pushed him further down a path of self-discovery than he had ever been before. In the process, he discovered much about his body and his mind. The experience upended all of his previously held beliefs and had him questioning all that matters in life. His quest for harmonizing the mind, body, and soul had begun. The same blood clots that nearly took his life also saved him—in ways no one expected.
The first part of this journey saw Steven and his wife, Jenn, moving from New Jersey to the west coast of Florida. Realizing how precious life is, they decided there was no more waiting for the right time to do things. The right time became now.
To this day, he pursues the now and takes nothing for granted.
About the Author
STEVEN BOVÉ, CFP®, CFA®, MSFS, is a graduate of Saint Lawrence University. Steven considers himself a financial planner by day and a healer by night; finance is his vocation, and healing is his passion. He lives in Florida with his wife, Jenn.